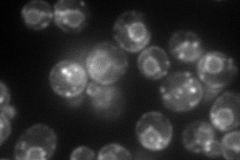
YLR100W
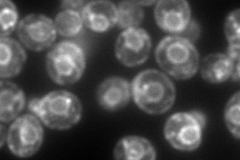
YLR100W
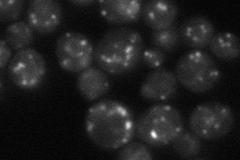
YLR100W
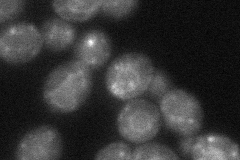
YLR100W
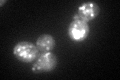
YLR100W
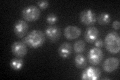
YLR100W

View description
3-keto sterol reductase, catalyzes the last of three steps required to remove two C-4 methyl groups from an intermediate in ergosterol biosynthesis; mutants are sterol auxotrophs
Localization:
Intensity:
Fold change:
Significance:
-
C’ GFP library in SD

punctate54.76 -
N' NOP1pr-GFP in SD
ER,punctate119.937 -
N' TEF2pr-mCherry in SD
ER,punctate223.333 -
N' NATIVEpr-GFP in SD
punctate44.9808 -
N' TEF2pr-VC and Cyto-VN in SD
ER,punctate46.0157 -
C’ GFP library in SD+DTT
punctate61.051.11No -
C’ GFP library in SD+H2O2

punctate58.331.06No -
C’ GFP library in Starvation Media
punctate59.941.09No -
C’ GFP library on the background of Pup2-DaMP

punctate -
C’ GFP library on the background of CCT mutant

punctate56.46311.03107No
